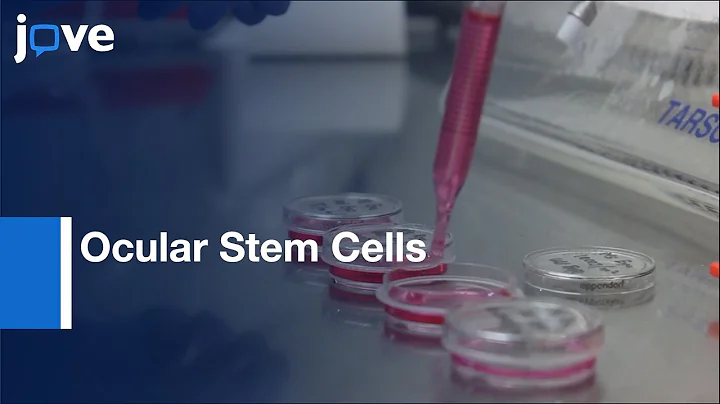
Oxidative Damage in Ocular Stem Cells in Response to (UV-C) Damage | Protocol Preview

External Source
Production & Detection Of Reactive Oxygen Species (ros) In Cancers L Protocol Preview
Synopsis
Watch the Full Video at ...
Download Options
Choose a download method below. All links open in new tabs.
| Service | Features | Action |
|---|---|---|
| SaveFrom |
MP4 & MP3 • HD Quality • Browser Extension Available
|
Download |
Security Notice: These are third-party services. We recommend using antivirus software and being cautious of pop-up ads.